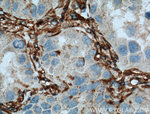
VAP1 Antibody in Immunohistochemistry (Paraffin) (IHC (P))

Search
Proteintech
VAP1 Polyclonal Antibody
{{$productOrderCtrl.translations['antibody.pdp.commerceCard.promotion.promotions']}}
{{$productOrderCtrl.translations['antibody.pdp.commerceCard.promotion.viewpromo']}}
{{$productOrderCtrl.translations['antibody.pdp.commerceCard.promotion.promocode']}}: {{promo.promoCode}} {{promo.promoTitle}} {{promo.promoDescription}}. {{$productOrderCtrl.translations['antibody.pdp.commerceCard.promotion.learnmore']}}

Please note: We are reviewing Western blot images included in the antibody testing data in our catalog, including those provided by third parties. Unless expressly labeled or annotated as “raw-unedited”, Western blot images included in the antibody testing data in our catalog may have been edited, optimized or otherwise adjusted for presentation.
产品信息
14365-1-AP
种属反应
宿主/亚型
分类
类型
抗原
偶联物
形式
浓度
规格
纯化类型
保存液
内含物
保存条件
运输条件
产品详细信息
Immunogen sequence: ATYVDWHFL LESQAPKTIR DAFCVFEQNQ GLPLRRHHSD LYSHYFGGLA ETVLVVRSMS TLLNYDYVWD TVFHPSGAIE IRFYATGYIS SAFLFGATGK YGNQVSEHTL GTVHTHSAHF KVDLDVAGLE NWVWAEDMVF VPMAVPWSPE HQLQRLQVTR KLLEMEEQAA FLVGSATPRY LYLASNHSNK WGHPRGYRIQ MLSFAGEPLP QNSSMARGFS WERYQLAVTQ RKEEEPSSSS VFNQNDPWAP TVDFSDFINN ETIAGKDLVA WVTAGFLHIP HAEDIPNTVT VGNGVGFFLR PYNFFDEDPS FYSADSIYFR GDQDAGACEV NPLACLPQAA ACAPDLPAFS HGGFSHN (408-763 aa encoded by BC050549 )
靶标信息
Copper amine oxidases catalyze the oxidative conversion of amines to aldehydes in the presence of copper and quinone cofactor. The product is a major protein on the adipocyte plasma membrane. It has adhesive properties and also has functional monoamine oxidase activity. A pseudogene for this gene has been discribed and is located approximately 9-kb downstream.
仅用于科研。不用于诊断过程。未经明确授权不得转售。
生物信息学
蛋白别名: Amine oxidase [copper-containing] 3; Amine oxidase copper-containing 3; amine oxidase, copper containing 3 (vascular adhesion protein 1); Copper amine oxidase; HPAO; membrane primary amine oxidase; placenta copper monamine oxidase; Semicarbazide-sensitive amine oxidase; SSAO; unnamed protein product; VAP-1; Vascular adhesion protein 1; VP97
基因别名: AOC3; HPAO; SSAO; VAP-1; VAP1
UniProt ID: (Rat) O08590, (Mouse) O70423
Entrez Gene ID: (Human) 8639, (Rat) 29473, (Mouse) 11754




